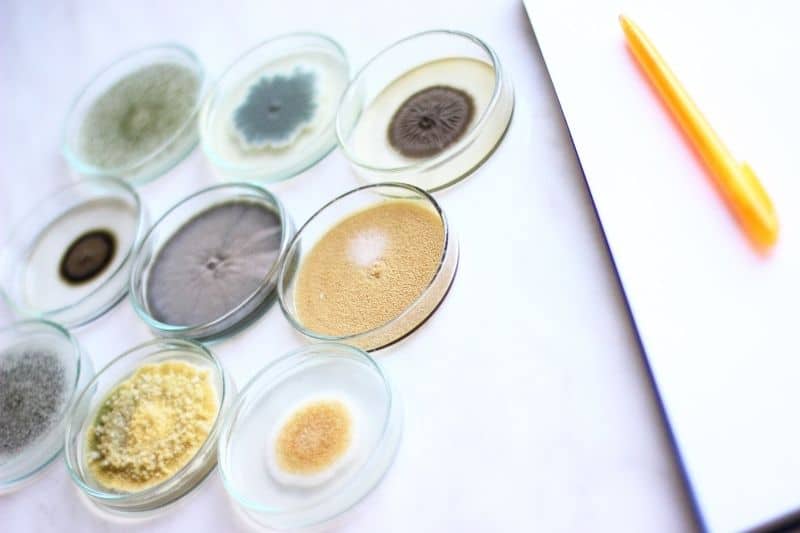
Pilz beim Pferd! Hautpilz schnell erkennen

If you are looking for Hautpilz beim Pferd – Natürlich & effektiv behandeln! you’ve visit to the right web. We have 33 Pics about Hautpilz beim Pferd – Natürlich & effektiv behandeln! like Hauterkrankung – Tierarztpraxis S. Dinklages Webseite!, Hauterkrankung – Pferdepraxis S. Dinklages Webseite! and also Pilze beim Pferd erkennen und behandeln – EquidocsEquidocs. Here it is:
Hautpilz Beim Pferd – Natürlich & Effektiv Behandeln!

pferde-freundschaften.de
Hautpilz Beim Pferd: Erkennen, Behandeln Und Vorbeugen

saltisept.de
Pilz Beim Pferd! Hautpilz Schnell Erkennen

www.pferdefluesterei.de
pferd pilz hautpilz erkennen schnell werde verraten geheimtipp großen aber einen
Pilz Beim Pferd (hautpilz)

www.gutefrage.net
pferd pilz hautpilz
Pferd Pilz Erkennen – Information Online

doni.manasquanbeachhouse.com
Hausmittel Gegen Haarlinge Beim Pferd – Information Online

andi.manasquanbeachhouse.com
Hygiene Im Stall | PM-Forum Digital Ausgabe 04/2015

www.pm-forum-digital.de
pferde pilz dauerhaft eingedeckt ende winters anfällig decken schmutzigen pilzerkrankungen gerade
Pilz Beim Pferd Behandeln & Vorbeugen ⇒ Tipps Vom Profi!

kristallkraft-pferdefutter.de
Hauterkrankung – Pferdepraxis S. Dinklages Webseite!

pferdepraxis.jimdo.com
hauterkrankung milben haarlinge kopf hautpilz kahle hauterkrankungen
Pemphigus Foliaceus (auto-immune Hautkrankheit) – Autoimmunkrankheiten

www.monvt.eu
pemphigus foliaceus hautkrankheit pferd dermatose immune katze
Pilz Beim Pferd – Hautpilz Erkennen Und Behandeln

www.peticare.at
pferd hautpilz pelle cavallo pilz funghi grasmilben milben milbenbefall malattie durch bestellt morgen heute geliefert pferdepflege
Pilze Beim Pferd Erkennen Und Behandeln – EquidocsEquidocs

www.equidocs.de
pferd pilz behandeln erkennen pilze perfekter nährboden wunde
Hautpilz Beim Pferd: Behandlung & Hausmittel

www.tiergesund.de
Pilz Beim Pferd! Hautpilz Schnell Erkennen

www.pferdefluesterei.de
pferd pilz mindset meinung verstehen pferdemenschen pferde jetzt
Pilz Pferd – AnoKath

www.anokath.com
Achtung Mauke! Richtig Behandeln Und Vorbeugen | Pferd, Tinker Pferd

www.pinterest.com
mauke pferd behandeln vorbeugen achtung pferde hautpilz krankheit sieht
Impfungen – Tierärztliche Gemeinschaftspraxis

www.tierarztpraxis-zuck-ehrenfels.de
Hauterkrankung – Tierarztpraxis S. Dinklages Webseite!

pferdepraxis.jimdo.com
hautpilz hauterkrankungen hauterkrankung
Pilz Beim Pferd! Hautpilz Schnell Erkennen

www.pferdefluesterei.de
pferd pilz erkennen schnell hautpilz beim dauern richtigen bist genau woran medikamente
Kleine Plagegeister: Wenn Milben Das Pferd Befallen

www.st-georg.de
pferd milben milbenbefall pferdebein georg kleine bein schwellung befallen plagegeister wenn beispiel beginnender anzeichen
Ekzem Oder Vielleicht Pilz? – Forum Pferd.de

www.pferd.de
pilz ekzem pferd vielleicht
Pilz Beim Pferd Erkennen – Tiergesund.de

www.tiergesund.de
Pilz Beim Pferd! Hautpilz Schnell Erkennen
www.pferdefluesterei.de
pferd pilz
Ekzem Oder Vielleicht Pilz? – Forum Pferd.de

www.pferd.de
pferd pilz ekzem vielleicht tapatalk
Pilze Beim Pferd Erkennen Und Behandeln – EquidocsEquidocs

www.equidocs.de
pferd erkennen behandeln pilze
Pilz Beim Pferd Mit ARAN-YA Nachhaltig Bekämpfen

www.aran-ya.de
Pilz Beim Pferd – Symptome, Ursachen & Behandlung | Ehorses Magazin (2023)

maglydesign.com
Mein Pferd Hat Mauke Und Pilz? (Gesundheit, Pferde, Pilze)

www.gutefrage.net
pilz pferd mauke gegen antwort
Pilz Beim Pferd! Hautpilz Schnell Erkennen

www.pferdefluesterei.de
pferd pilz erkennen hautpilz beim loswerden
Hauterkrankungen – Stumpfes Fell, Schuppige Haut Oder Kahle Stellen

www.mein-pferd.de
pferd hauterkrankungen schuppige fell kahle stumpfes pilzinfektion
Pilz Beim Pferd – Symptome, Ursachen & Behandlung | Ehorses Magazin

www.ehorses.de
Pilz Beim Pferd Behandeln & Vorbeugen ⇒ Tipps Vom Profi!

kristallkraft-pferdefutter.de
Pilz Beim Pferd Mit ARAN-YA Nachhaltig Bekämpfen

www.aran-ya.de
Pferd pilz erkennen schnell hautpilz beim dauern richtigen bist genau woran medikamente. Hauterkrankung milben haarlinge kopf hautpilz kahle hauterkrankungen. Pferd pilz hautpilz erkennen schnell werde verraten geheimtipp großen aber einen
